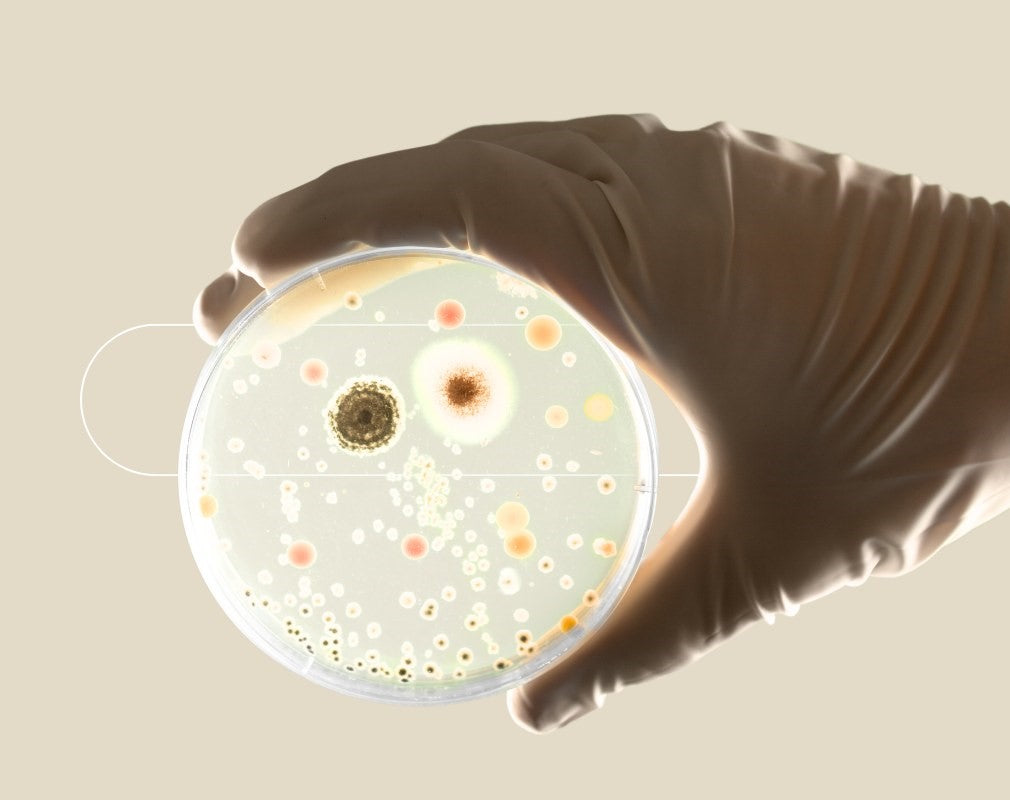

It is in your microbiome's best interest to look after you, as you are home to these trillions of tiny microbes!
Our microbiome does many important things for our health and survival.
This includes regulating and maintaining your digestive and immune systems, protecting you against germs and diseases, breaking down food to release energy and produce vitamins, as well as influencing emotional well-being through secretion and regulation of hormones and neurotransmitters.
Microbiome and the immune system
Your microbiome plays a critical role in immune health. First by providing a protective barrier along the gut wall, preventing harmful microbes or toxins from entering the blood stream, whilst simultaneously allowing vitamins and nutrients to pass through. Secondly, by continuously regulating your immune systems defenses by producing molecules and chemical signals that interact and communicate with your immune cells. This back-and-forth communication between your microbiome and your immune system allows for swift and effective action against harmful agents (pathogens), whilst also preventing your body from overreacting to harmless substances (known as autoimmune conditions).
Microbiome and the endocrine system
The microbes in your body also play important roles in the breakdown of molecules and nutrients into biologically ‘active’ versions that are useful to our bodies. Without bacteria performing these intermediate steps our bodies would be much less efficient at using some of these molecules. Estrogen, which is crucial for the regulation of both men and women’s reproductive health, is one such example. Vitamin D is another example of a molecule which needs to be broken down into a biologically ‘active’ form, and a recent study found that gut bacteria are closely associated with active vitamin D levels.
Microbiome and the digestive system
As stated above, the microbes in your gut break down the nutrients in your food. They also strengthen the gut lining/barrier preventing toxins and pathogens from entering your blood stream. A healthy gut microbiome aids normal digestive transit and healthy bowel habits also.
Microbiome and the brain
You will also be amazed to know that many strains of gut bacteria produce and respond to the same neurochemicals that we do! For example, GABA, serotonin, norepinephrine, dopamine, acetylcholine and melatonin, just to name a few, are all influenced by your microbiome. GABA is crucial for keeping brain networks properly balanced and inducing relaxation and sleep; dopamine and norepinephrine help to regulate our motivation and feelings of reward; acetylcholine, affects our memory, movement and ability to concentrate; and serotonin is critical to feelings of wellbeing and calmness.
Microbiome and the skin
The microbes on your skin form a layer of protection on the surface of your body. They help strengthen the skin barrier stopping your skin from becoming itchy, red, raw, and dry. They also keep the number of pathogens such as acne-causing microbes on your skin to a minimum, keeping your skin pimple free and healthy.

A state of disruption
When the microbiome is in a state of disruption (i.e. when the wrong types of bacteria are present in the wrong quantities) your microbiome will struggle to provide these health benefits.
Instead, you may end up with a bacterial composition which causes you negative health effects. A lack of beneficial microbes can, for example, result in hyper-immune system reactions and systemic inflammation in the gut. Further, some microbes can actively trigger the release of pro-inflammatory molecules called cytokines. Inflammatory cytokines can disrupt brain neurochemistry and make people more vulnerable to anxiety, depression and decreased cognitive function.
These are just a few of the most obvious functions that your microbiome performs. Year upon year, researchers are uncovering more and more links between various aspects of human health and the microbiome. Therefore, making sure your microbiome stays healthy is crucial for your health and wellbeing.

Using powerful and bioactive advanced probiotics, biomiq's gut health formulations work hard to rebalance your natural microbiome.
Read our other blogs
-
But aren't microbes bad? they make you sick - don't they?
Read ArticleNow scientists and doctors know better and have better technology, which enables them to study the the bacteria that help us to stay healthy. What they have found is that most bacteria do not cause disease when there is just the right amount of them.
-
Microbiome Dysbiosis: what happens when the gut microbiome is disturbed?
Read ArticleMicrobes regulate our digestive and immune systems, protect against germs, break down food to release energy, produce vitamins, and even influence behaviour. However, this balance can be disrupted by several factors.
-
How to create a healthy microbiome.
Read ArticleThe bacteria within your body are absolutely crucial to your health and wellbeing. So, making lifestyle choices that will benefit and promote a healthy microbiota is a great way to reduce your risk of health complications.


